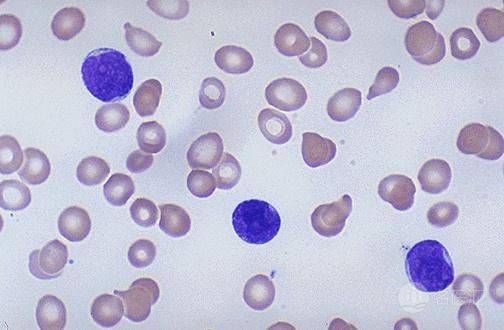
慢性淋巴细胞白血病症状,儿童淋巴细胞白血病的早期症状

慢性淋巴性白血病是一种难以治愈的疾病吗?
我们知道白血病在以前就认为是一种无法治愈的疾病。慢性淋巴性白血病简称慢淋,是白血病分类当中的一种类型。是一种单克隆性小淋巴细胞疾病,细胞以正常或高于正常的速率复制增值,大量蓄积在骨髓、血液、淋巴结以及其他器官,最终导致正常的造血功能衰竭的低度恶性疾病。这种细胞形态上成熟但是免疫学不成熟,功能不全的细胞。慢淋的进展期可导致骨髓功能衰竭和直接的组织器官浸润。
乏力,淋巴结肿大,脾大,贫血就能诊断为慢性淋巴性白血病的吗?
症状和体征往往晚些出现。慢淋是一种发生在中年以上人的疾病,约90%的患者年龄超过50岁,平均年龄为65岁。许多病人是偶然发现淋巴细胞增多。最早出现的症状常常是乏力、疲倦、体力活动时气促。浅表淋巴结特别是颈部淋巴结肿大,常首先引起病人的注意,晚期成串成堆,直径可达2~3cm,无压痛、质硬、可移动。肠系膜或腹膜后淋巴结可引起腹部或泌尿系统症状。脾轻至中度肿大,肝亦可肿大,但不如慢粒显著。稍晚出现食欲减退、消瘦、低热、盗汗、贫血等症状。约10%或以上病人可发生自体免疫性溶血性贫血,此时贫血常较严重,并可出现黄疸。晚期可有皮肤紫癜和出血倾向,易感染,尤其是呼吸道感染。这与正常免疫球蛋白的产生减少有关,可能成为死亡的直接原因。另外胃肠道、骨骼系统可出现不同程度的损害。有些病人有皮肤瘙痒。偶见白血病性皮肤浸润,表现为紫红色或棕红色结节或皮肤增厚。全身皮肤对以发红、扁桃体、唾液腺或泪腺也可肿大。
慢性淋巴性白血病的病程长短很不一致,从1~2年至10余年不等,平均约3~4年(从诊断成立时算起)。其主要死亡原因为骨髓功能衰竭引起的严重贫血、出血或感染,以肺部感染最为多见。虽然早期的症状不算明显,多数人都容易忽略。若早期出现乏力,疲倦,淋巴结肿大,应及时去医院检查,以排除是否是血液系统疾病。
更多疾病知识,以及预约挂号、就医咨询等免费就医服务,可关注名医汇官方微信“mingyihuinet”(复制此名称,进入微信搜索添加即可)。
名医汇,让病人家庭轻松一点!提供预约挂号、网上咨询、陪诊服务等多项免费就医服务,依据患者真实的就医分享与点评,倾力打造“名医排行榜”,精准读取你的就医需求!